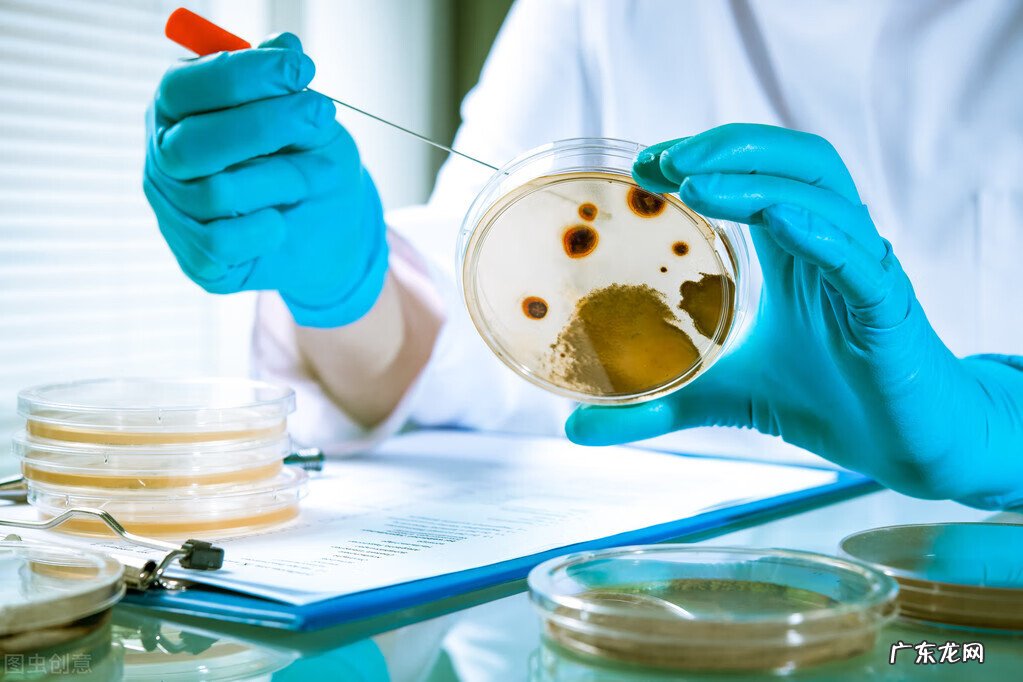
怎么正确使用卫生巾步骤 如何使用卫生巾?

文章插图
卫生巾在使用前需要先洗手 , 我们的手上拥有很多的细菌 , 如果在使用卫生巾之前没有将手洗干净的话 , 细菌就会跑到卫生巾上面 , 跟着侵犯外阴部 , 阴道 , 从而引起阴道炎 , 宫颈炎等一系列的妇科疾病!
文章插图
并且不要把卫生巾放在卫生间里面 , 因为卫生间里面大多数都是出于阴暗潮湿的地方 , 这样的环境聚集了很多的细菌 , 如果一直把卫生巾放在厕所里面 , 尤其是已经开封的卫生巾 , 那就很容易受到细菌感染 , 到时候再使用容易导致炎症的发生!

文章插图
【怎么正确使用卫生巾步骤 如何使用卫生巾?】
有些可能比较节省 , 舍不得用好的卫生巾 , 觉得这样一个经期会用掉好多钱 , 但其实好的卫生巾吸收好 , 不仅可以让女人在整个经期舒适很多 , 而且还可以有效防止质量不好的卫生巾引起私处瘙痒 , 为了自己的身体着想 , 请不要再健康方面省事!
- 孩子不喜欢写作业怎么办?教你一招就根治! 孩子不喜欢写作业
- 广汽丰田致炫两厢怎么样 丰田两厢车致炫怎么样
- 三线仓鼠怎么养? 三线鲃好养吗
- 卵泡质量好不好怎么看 如何看卵泡质量
- 淘宝怎样打单 淘宝打单怎么打
- 如何阻止猫爬上汽车? 猫爬车上怎么解决
- 孩子是过敏体质怎么调理
- 槐茂甜面酱怎么吃 槐茂甜面酱怎么辨真假
- 金龙鱼爆鳞 金鱼爆鳞是怎么回事
- 尾箱凹进去了能处理好吗 后尾箱撞凹了怎么处理
特别声明:本站内容均来自网友提供或互联网,仅供参考,请勿用于商业和其他非法用途。如果侵犯了您的权益请与我们联系,我们将在24小时内删除。
